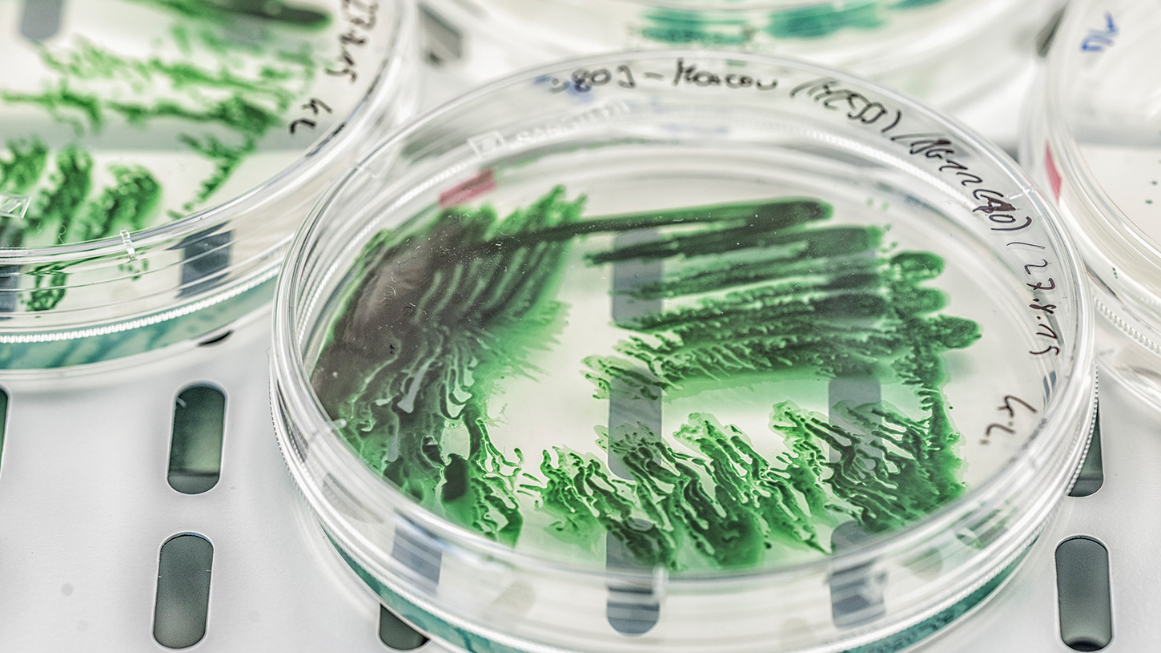
Cyanobakterien können als Biofabriken dienen.

Wie giftiges Guanidin zum Treibstoff steuerbarer Zellfabriken wird
Das eigentlich toxische Guanidin dient Cyanobakterien als Nährstoff, gesteuert von einem molekularen Schalter. Mit der Entdeckung der zugrunde liegenden Mechanismen eröffnen Forschende neue Wege für CO2-neutrale Biofabriken.
Cyanobakterien tragen entscheidend zu den globalen Kohlenstoff- und Stickstoffkreisläufen bei und können eine zentrale Rolle in der CO2-neutralen Produktion von Chemikalien und Kraftstoffen spielen. Forschende des Helmholtz-Zentrums für Umweltforschung (UFZ) haben nun gemeinsam mit Partnern eine überraschende Fähigkeit dieser Mikroben aufgeklärt: Sie können Guanidin, bisher vor allem als giftiges Reagenz bekannt, als alleinige Stickstoffquelle nutzen. Diese Entdeckung erweitert nicht nur unser Verständnis des Stickstoffstoffwechsels von Cyanobakterien, sondern eröffnet auch völlig neue Möglichkeiten, biotechnologische Produktionsprozesse effizient und kostengünstig zu steuern.
Vom Giftstoff zum Nährstoff
Wie funktioniert das? Cyanobakterien nehmen Guanidin gezielt über ein neu entdecktes Transportsystem auf, selbst wenn nur winzige Mengen verfügbar sind. Überschüssiges Guanidin wird über ein weiteres System wieder aus der Zelle transportiert, um Schäden zu vermeiden. Im Inneren spaltet, wie bereits zuvor bekannt, ein spezielles Enzym die Verbindung in Ammonium und Harnstoff, die direkt für Wachstum und Stoffwechsel genutzt werden können. Diese Mechanismen sind in vielen Cyanobakterien verbreitet und zeigen, dass Guanidin in natürlichen Lebensräumen offenbar eine größere Rolle spielt, als bisher angenommen.
Molekulare Schalter als Werkzeug für die Bioökonomie
Besonders spannend für die Bioökonomie: Die Verwertung von Guanidin wird über einen sogenannten Riboswitch gesteuert, ein molekulares Schaltelement, das direkt auf die Verbindung reagiert. Forschende nutzen diesen Mechanismus, um Gene präzise ein- oder auszuschalten. Da Guanidin günstig und bereits in kleinen Mengen wirksam ist, ist es ideal für industrielle Anwendungen. So können Cyanobakterien als grüne Zellfabriken dienen, die lichtgetrieben und präzise steuerbar aus CO2 chemische Bausteine produzieren.
hb


